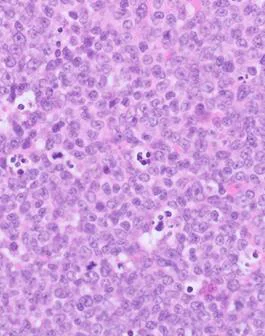

Indications for lymph node biopsy
Fine needle aspiration of lymph node is an inexpensive and relatively straightforward starting point for investigating abnormal lymph nodes but, in the event of poor cell harvest or an otherwise inconclusive result, biopsy is the next step.
Histopathology is also more likely to be required to make a diagnosis of lymphoma in cats compared to dogs [Amores-Fuster et al 2015]. Indications for lymph node biopsy are:
i) One or more lymph nodes abnormally enlarged and/or firmer than normal
ii) Part of the staging process for an already known
neoplastic process
iii) Further characterisation of a tumour diagnosed by FNA, especially lymphoma typing

Fig 1 – Lymph node. Red area depicts a diffuse lesion – the likelihood of sampling representative tissue is high.

Fig 2 – Lymph node. Red areas depict multifocal lesions. You may or may not be lucky in sampling diagnostic tissue.
Types of lymph node biopsy
i. Excisional: The entire affected lymph node is removed and submitted for histopathology
This is the pathologist’s preference. We’re not being greedy – it just removes all doubt that the sample may not be representative. Some lymph node lesions are localised or multifocal and such an uneven pattern is more likely to be appreciable when we have the whole node to examine. Some metastatic tumours may only be present in small areas of the node and even some lymphomas may not be diffuse (e.g. early stage, emerging).
ii. Incisional, e.g. wedge of lymph node
This may be enough in many cases, especially in diffuse nodal lesions such as reactive lymphoid hyperplasia and most lymphomas. However, as mentioned above, this method may not capture early metastatic neoplasia or lesions that are not always diffuse, such as lymphadenitis, so there are limitations.
iii. Tru-cut biopsy
We do not receive many Tru-cut biopsies of lymph node and we would not recommend this technique as there is even more risk of not capturing potentially pertinent lesions. In a very enlarged lymph node, where there is more chance of reaching a diagnosis, there are still potential drawbacks, such as an inability to confirm or classify a lymphoma. Tru-cut biopsies are prone to fragmentation and, in small fragments, isolated germinal centres may appear very similar to small portions of tissue affected with lymphoma, i.e. they are impossible to distinguish without wider architectural context (Fig 1 and 2).
Furthermore, Tru-cut biopsies may not sample sufficient volume of tissue for further testing, such as immunohistochemistry or PARR.
Considerations when sampling lymph node
- Be as gentle as you can when handling lymph node – lymphocytes are fragile and lymph node stroma is not robust, so the cells are prone to crushing, which can significantly hamper interpretation.
- We often receive enlarged mesenteric lymph nodes from dogs (or cats) with clinical signs of gastrointestinal disease, particularly
young dogs. In most of these cases, the lymph node is reactive but this may be normal in a young dog where there is exposure to novel antigens. While lymph node may be helpful, it is
unlikely to be diagnostic, particularly without samples of gastrointestinal tract, which are more likely to be rewarding.
- Consider retaining a small piece of node fresh (in the fridge) or culture at the same time, in case it turns out to be inflammatory or infectious. Especially in cats, you could also keep a small piece frozen, particularly if mycobacterium is a potential differential. Fresh tissue is the preferred sample for mycobacterium culture and/or PCR, although there is still a high risk of false negatives. Bear in mind that freezing tissues can kill many bacterial organisms so frozen samples are often no longer of use for culture. However, mycobacterium tends to be more robust, and freezing should not affect molecular methods such as PCR.
Submitting the biopsy
Lymph node for histopathology can be submitted as normal in 10% neutral buffered formalin. Before fixing you could consider taking some impression smears (gently!).
Histopathology pattern examples
Figs 3-5 are histological images from biopsies, highlighting why the area sampled can have an impact on interpretation and diagnosis.
Reference
Amores-Fuster I, Cripps P, Graham P, Marrington AM and Blackwood L (2015) the diagnostic utility of lymph node cytology samples in dogs and cats. Journal of Small Animal Practice 56:125-129.

Fig 3. Reactive lymphoid hyperplasia in a canine lymph node. Yellow box shown in Fig 4.
Fig 4. Area within yellow box in Fig 3. This is a germinal centre, a normal feature of a reactive, hyperplastic lymph node. If we only had this area in a small biopsy, it would be more difficult to rule out lymphoma, i.e. without the broader context.

Fig 5. This is T-cell rich B-cell lymphoma in a cat’s lymph node. The tumour is outlined in yellow. The rest of the node is hyperplastic so a wedge from the blue area would return a diagnosis of lymphoid hyperplasia and not neoplasia.
Related Posts
Organ of the Month: Mammary Glands
Organ of the month: Mammary Glands I. Indications for biopsy/pathological evaluation Mammary lesions are among…
Organ of the Month: PART II – The Male Reproductive Tract
Organ of the month: PART II – The Male Reproductive Tract I. Indications for biopsy/pathological…
Diagnosis of Canine Hypercortisolism
Diagnosis of Canine Hypercortisolism Introduction Hypercortisolism is a common endocrinopathy in dogs and is also…
Canine and Feline Blind Bronchoalveolar Lavage (BAL)
Canine and Feline Blind Bronchoalveolar Lavage (BAL) Common indications for blind BAL: Chronic cough Chronic…
